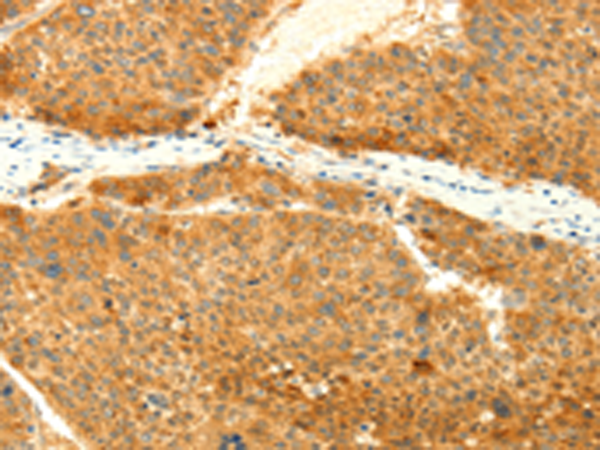
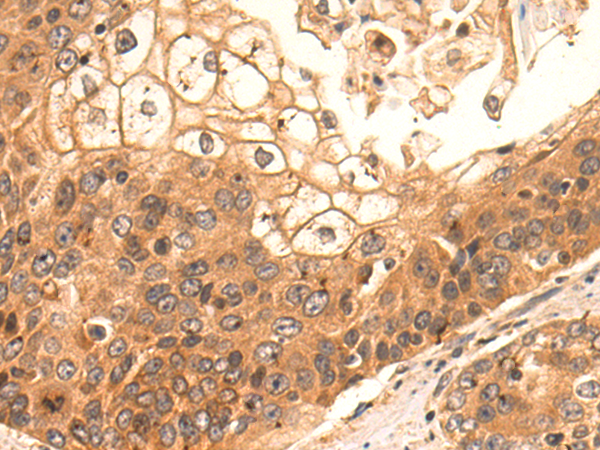

-
分类: 科研抗体货号: P07609别名: CIS6; CISH6; Cish5; SOCS-5应用: IHC反应种属: Human, Mouse
-
分类: 科研抗体货号: P07631别名: SYT12, sytXI应用: IHC反应种属: Human, Mouse, Rat
-
分类: 科研抗体货号: P07608别名: CIS2; SSI2; Cish2; SSI-2; SOCS-2; STATI2应用: IHC反应种属: Human, Mouse, Rat
-
分类: 科研抗体货号: P07629别名: sytVI应用: IHC反应种属: Human, Mouse, Rat
-
分类: 科研抗体货号: P07606别名: RIC4; SEC9; SNAP; RIC-4; SNAP-25; bA416N4.2; dJ1068F16.2应用: WB,IHC反应种属: Human, Mouse, Rat
-
分类: 科研抗体货号: P07628别名:应用: WB,IHC反应种属: Human, Mouse, Rat
-
分类: 科研抗体货号: P07641别名:应用: WB,IHC反应种属: Human, Mouse, Rat
-
分类: 科研抗体货号: P07627别名: HsT1192应用: WB,IHC反应种属: Human, Mouse, Rat
-
分类: 科研抗体货号: P07639别名: p72-Syk应用: IHC反应种属: Human, Mouse, Rat
-
分类: 科研抗体货号: P07626别名: SytIII应用: IHC反应种属: Human, Mouse, Rat

鄂公网安备42018502007531号
鄂公网安备42018502007531号

